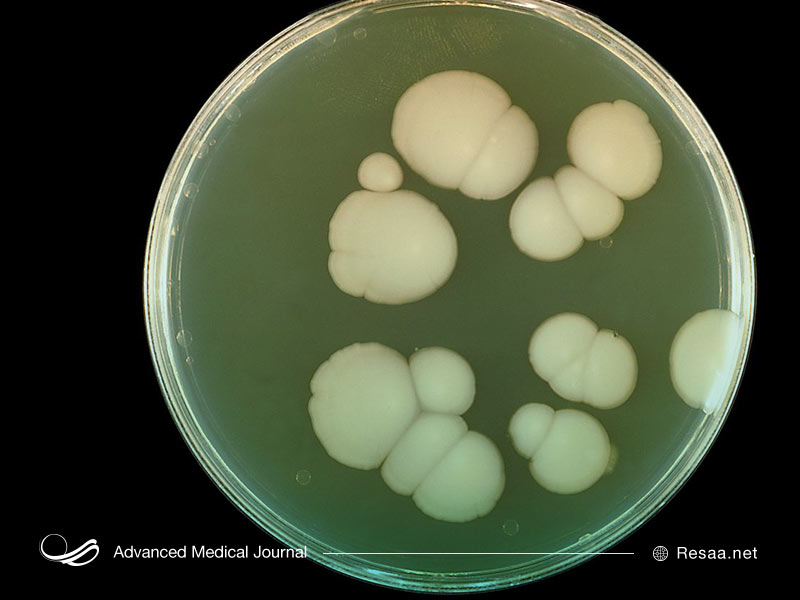
عفونتهای باکتریایی

واژینیت یک اصطلاح پزشکی است که برای توصیف اختلالات التهابی واژن به کار برده میشود. این اختلالات مختلف باعث عفونت یا التهاب واژن میشود. واژن به بخش داخلی دستگاه تناسلی زنان گفته میشود. واژینیت میتواند در نتیجه عفونت ناشی از ارگانیسم هایی مانند باکتری، قارچها یا ویروسها باشد. تحریکات ناشی از مواد شیمیایی موجود در کرمها، اسپریها یا حتی لباسهایی که با این ناحیه در تماس هستند نیز، میتوانند منجر به واژینیت شوند. در برخی موارد، واژینیت از ارگانیسمهایی که بین شرکای جنسی منتقل میشوند، خشکی واژن و کمبود استروژن ناشی میشود.

فهرست مطالب
- 1 آیا ترشحات واژن طبیعی است؟
- 2 متداول ترین انواع واژینیت چیست؟
- 3 عفونت های کاندیدا یا مخمر(قارچی) چیست؟
- 4 واژینوز یا واژینیت باکتریایی چیست؟
- 5 تریکومونیازیس ، کلامیدیا و واژینیت ویروسی چیست؟
- 6 واژینیت غیر عفونی چیست؟
- 7 واژینیت آتروفیک چیست؟
- 8 علائم واژینیت چیست؟
- 9 واژینیت چگونه درمان میشود؟
- 10 درمورد درمان واژینیت چه سوالاتی را باید از پزشک خود بپرسم؟
- 11 عوامل خطر برای عفونت کاندیدای واژن چیست؟
- 12 چگونه می توانم از ایجاد واژینیت جلوگیری کنم؟
آیا ترشحات واژن طبیعی است؟
در حالت طبیعی، واژن ترشحاتی ایجاد میکند که معمولاً به صورت شفاف یا کمی کدر، غیر تحریککننده و با بوی بسیار کم است. در طی چرخه قاعدگی طبیعی نیز، میزان و قوام ترشحات تغییر میکند. در یک زمان از ماه ممکن است مقدار کمی ترشحات بسیار نازک یا آبکی وجود داشته باشد. در زمان دیگری، (معمولاً قسمت آخر چرخهی قاعدگی) ممکن است ترشحات ضخیمتر و گستردهتری ایجاد شود. همهی این ترشحات طبیعی هستند.
ترشحات واژینال که بوی زیادی دارند یا معمولاً با سوزش و خارش همراه هستند، ترشحات غیرطبیعی محسوب میشوند. سوزش در این حالت، میتواند مانند عفونت مثانه احساس شود. خارش ممکن است در هر زمان از روز وجود داشته باشد، اما اغلب شب هنگام بیشتر آزار دهنده است. این علائم اغلب با مقاربت جنسی بدتر میشوند. اگر تغییری در میزان، رنگ یا بوی ترشحات ایجاد شده وجود داشته باشد که بیش از چند روز ادامه یابد، باید به پزشک متخصص مراجعه کنید.
متداول ترین انواع واژینیت چیست؟
متداول ترین انواع واژینیت عبارتند از:
- واژینیت کاندیدا یا مخمر(قارچی)
- واژینوز باکتریال
- واژینیت تریکومونیازیس
- واژینیت کلامیدیا یا سوزاک
- واژینیت ویروسی
- واژینیت غیر عفونی
- واژینیت آتروفیک
هر یک از این عفونتهای واژن میتوانند علائم متفاوتی داشته باشند یا به هیچ وجه علائمی نداشته باشند. در حقیقت، تشخیص حتی برای یک پزشک بالینی باتجربه میتواند مشکل باشد. گاهی اوقات ممکن است، بیش از یک نوع واژنیت همزمان وجود داشته باشد.
برای درک بهتر این هفت نوع اصلی واژینیت، به طور خلاصه به هریک از آنها و نحوهی درمان آنها نگاهی میاندازیم.
عفونت های کاندیدا یا مخمر(قارچی) چیست؟
عفونتهای مخمری واژن همان چیزی است که اکثر خانمها با شنیدن اصطلاح واژینیت به آن فکر میکنند. عفونتهای مخمر توسط یکی از گونههای مختلف قارچ به نام کاندیدا ایجاد میشود. کاندیدا به طور معمول در واژن و همچنین در دهان و دستگاه گوارش زنان و مردان زندگی میکند. عفونت زمانی ایجاد میشود که تعداد کاندیدا به طور معمول افزایش یابد و علائم آزار دهندهای ایجاد کند.
عفونتهای قارچی، ترشحات واژن غلیظ و سفید(پنیری شکل) ایجاد میکنند. اگرچه این ترشحات گاهی میتواند تا حدودی آبکی باشد، اما به طور کلی بیبو است. عفونتهای قارچی معمولاً باعث خارش و قرمز شدن واژن میشوند. حتی گاهی قبل از شروع ترشحات، واژن متورم میشود. زنان مبتلا به عفونت قارچی ممکن است بریدگیهای کوچکی در اندام تناسلی خود داشته باشند که هنگام ادرار دچار سوزش شدید شود.
اگر وجود مقداری قارچ در واژن زن طبیعی است، پس چه عواملی باعث ایجاد عفونت میشود؟ معمولاً هنگامی که تعادل میزان میکروارگانیسمها در سیستم تناسلی زنان بهم میریزد، عفونت رخ می دهد. به عنوان مثال، ممکن است یک زن برای درمان عفونت دستگاه ادراری از آنتیبیوتیک استفاده کند. این آنتیبیوتیک باکتریهای مفیدی را که به طور معمول تعادل قارچی را حفظ میکند، از بین می برد. در نتیجه، قارچها بیش از حد رشد میکنند و التهاب و عفونت رخ میدهد. از دیگر عواملی که میتواند این تعادل را بر هم زند، بارداری است که باعث تغییر سطح هورمون میشود. دیابت نیز باعث میشود مقدار زیادی قند در ادرار و واژن وارد شود. این قند تغذیهی مناسبی برای رشد مخمرها است.
واژینوز یا واژینیت باکتریایی چیست؟
اگرچه قارچ نامی است که اکثر زنان میدانند، واژینوز باکتریایی در واقع شایعترین نوع عفونت واژن در زنان در سن باروری است. واژینوز باکتریایی اغلب باعث ترشحات واژن با بوی غیرطبیعی میشود. ترشحات معمولاً نازک و شیری است و بوی تند ماهی میدهد. این بو ممکن است بعد از مقاربت بیشتر احساس شود.
قرمزی یا خارش واژن از علائم رایج واژینوز باکتریایی نیست، مگر اینکه زن به عفونت همزمان قارچی نیز مبتلا شود. بعضی از خانمهای مبتلا به واژینوز باکتریایی به هیچ وجه علائمی ندارند و واژینیت تنها در طی یک معاینه معمول زنان و زایمان کشف میشود. واژینوز باکتریایی در اثر ترکیبی از چندین باکتری ایجاد میشود که به طور معمول در واژن زندگی می کنند. به نظر می رسد که این باکتریها نیز همانند کاندیدا، در هنگام بر هم خوردن تعادل pH واژن ، بیش از حد رشد میکنند. این رشد بیش از حد باعث ایجاد التهاب و عفونت میشود.
از آنجا که واژینوز باکتریایی ناشی از باکتری است و نه مخمر، دارویی که برای مخمر مناسب باشد در برابر باکتریهایی که باعث واژینوز باکتریایی می شوند موثر نیست. بنابراین، درمان نادرست یک بیماری میتواند علائم را بدتر کند.
واژینوز باکتریال عفونت مقاربتی نیست، اما بیشتر در افراد فعال جنسی مشاهده میشود. عوامل خطر برای واژینوز باکتریایی عبارتند از:
- شرکای جنسی جدید یا متعدد
- شستشوی نامناسب
- سیگار کشیدن
تریکومونیازیس ، کلامیدیا و واژینیت ویروسی چیست؟
تریکومونیازیس:
این مشکل توسط ارگانیسم ریز تک سلولی ایجاد میشود که به عنوان تک یاخته شناخته میشود. هنگامی که این ارگانیسم واژن را آلوده کند، می تواند باعث ترشحات مایع و زرد مایل به سبز شود. غالباً ممکن است این ترشحات بوی بدی داشته باشد. زنان مبتلا به واژینیت تریکومونال ممکن است از خارش و درد واژن و مجرا و همچنین سوزش هنگام ادرار شکایت داشته باشند. علاوه بر این، میتوان با مقاربت، در پایین شکم و واژن احساس ناراحتی و درد کرد. این علائم ممکن است بعد از دوره قاعدگی بدتر شود. با این حال ، بسیاری از زنان هیچ علائمی ندارند. درک این نکته مهم است که این نوع واژینیت از طریق مقاربت جنسی قابل انتقال است. برای موثر بودن درمان، شریک زندگی جنسی باید همزمان با بیمار معالجه شود. آنها باید به مدت هفت روز از رابطه جنسی خودداری کنند.
کلامیدیا:
کلامیدیا شایعترین عفونت مقاربتی است. متأسفانه، بیشتر زنان مبتلا به عفونت کلامیدیا علائمی ندارند و این امر تشخیص را دشوار میکند. ترشحات واژن گاهی اوقات با این عفونت وجود دارد، اما نه همیشه. بیشتر اوقات، یک زن ممکن است خونریزی خفیف را تجربه کند. به خصوص پس از مقاربت ،به دلیل وجود دهانه رحم خمیده و بسیار نرم در این افراد، وممکن است در قسمت تحتانی شکم و لگن، احساس درد داشته باشند . واژینیت کلامیدیا بیشتر در زنان جوان 18 تا 35 سال که روابط جنسی متعدد دارند شایع است. در حالی که عفونتهای کلامیدیا با داروهای آنتیبیوتیکی قابل درمان هستند، اما بهترین درمان برای کلامیدیا پیشگیری است. استفاده صحیح و مداوم از کاندوم، خطر ابتلا به کلامیدیا و سایر عفونتهای مقاربتی را کاهش میدهد. سوزاک، یک بیماری مقاربتی دیگر نیز میتواند علائم واژینیت ایجاد کند. شرکای جنسی برای جلوگیری از عفونت مجدد باید به طور مناسب ردیابی و درمان شوند.

واژینیت ویروسی:
ویروسها یکی از دلایل عمده واژینیت هستند. یک فرم ناشی از ویروس هرپس سیمپلکس اغلب فقط عفونت تبخال نامیده می شود. این عفونتها با تماس جنسی منتشر میشوند. علائم اصلی واژینیت تبخال، دردی است که با ضایعات یا زخم همراه است. این زخم ها معمولاً در مجرا یا واژن قابل مشاهده هستند اما گهگاه در داخل واژن قرار دارند و فقط در معاینه زنان مشاهده میشوند. شیوع HSV اغلب با استرس یا ناراحتی عاطفی همراه است. اگر رابطه جنسی دهانی انجام شود، واژنیت تبخال تناسلی میتواند بر حلق و دهان تأثیر بگذارد.
ویروس پاپیلومای انسانی :
منبع دیگر عفونت ویروسی واژن ویروس پاپیلومای انسانی یا HPV است. HPV، که گاهی به عنوان زگیل تناسلی نیز نامیده میشود، همچنین می تواند با مقاربت جنسی منتقل شود. این ویروس میتواند باعث رشد زگیلهای دردناک در واژن، راست روده و یا کشاله ران شود. این زگیلها معمولاً به رنگ سفید تا خاکستری هستند اما ممکن است صورتی یا بنفش نیز باشند. با این حال، زگیلهای قابل مشاهده همیشه وجود ندارند و وجود ویروس فقط در صورت غیرطبیعی بودن آزمایش پاپ اسمیر، اثبات میشود.

بسیاری از عفونتهایی که باعث واژینیت میشوند، میتوانند در طی رابطه جنسی بین زن و مرد منتشر شوند. استفاده از روشهای پیشگیری از بارداری مانع، مانند کاندوم، میتواند به کاهش خطر ابتلا به این عفونتها کمک کند. البته که این روشها محافظت صد در صد ندارند.
واژینیت غیر عفونی چیست؟
به طور غیرمعمول، یک زن بدون داشتن عفونت میتواند خارش، سوزش و حتی ترشحات واژن داشته باشد. شایعترین علت آن واکنش آلرژیک یا تحریک ناشی از اسپریهای واژن، دوش یا محصولات اسپرمکش است. با این حال، پوست اطراف واژن همچنین میتواند به صابونهای معطر، لوسیونها ، روانکنندههای جنسی، شویندهها و نرمکنندههای پارچه حساس باشد. علاوه بر این، استفاده طولانی مدت از محصولات موضعی بدون نسخه برای جلوگیری از بوی بد و خارش میتواند باعث ایجاد واژینیت شود. یک مثال دیگر، واژینیت التهابی است که با ترشحات واژن ضخیم ، موکوئیدی زرد تا سبز مشخص میشود که معمولاً در زنان یائسه دیده میشود.
واژینیت آتروفیک چیست؟
واژینیت آتروفیک که به آن علائم ادراری تناسلی یائسگی و آتروفی ولووژینال نیز گفته میشود، یکی دیگر از اشکال غیر عفونی واژینیت است. این نوع واژینیت از کاهش هورمونها ناشی میشود. واژن در این حالت خشک یا آتروفیک میشود. این امر در درجه اول در دوران یائسگی رخ میدهد. شیردهی و حالات پس از زایمان نیز میتوانند در آتروفی نقش داشته باشند. داروهایی مانند مهار کنندههای آروماتاز که در سرطان پستان استفاده میشود یا برخی داروهایی که در آندومتریوز استفاده میشود نیز میتوانند سطح استروژن را به شدت کاهش دهند و باعث آتروفی شوند. زن ممکن است متوجه درد (به ویژه با مقاربت جنسی)، خارش و سوزش واژن یا علائم فوریت ادرار و تکرر آن شود. درمانهای واژینال و خوراکی برای درمان موفقیت آمیز این بیماری در دسترس است.
علائم واژینیت چیست؟
علائم واژینیت بسته به علت ایجاد عفونت یا التهاب میتواند متفاوت باشد. بعضی از خانمها اصلاً علامتی ندارند. برخی از علائم شایع واژینیت عبارتند از:
- ترشحات غیر طبیعی واژن با بوی نامطبوع
- احساس سوزش در خارج از واژن در هنگام ادرار کردن
- خارش در اطراف قسمت خارجی واژن
- ناراحتی در حین مقاربت
واژینیت چگونه درمان میشود؟
کلید درمان مناسب واژنیت تشخیص صحیح است. این امر همیشه آسان نیست زیرا همان علائم میتوانند در اشکال مختلف واژینیت وجود داشته باشد. شما می توانید با توجه دقیق به علائمی که دارید و زمان بروز آنها، همراه با توصیف رنگ، قوام، مقدار و بوی هر نوع ترشحات غیرطبیعی، به پزشک در تشخیص کمک کنید. ما هرگز شستشوی بیش از حد را توصیه نمیکنیم. برخی از پزشکان درخواست میکنند که 24 ساعت قبل از ویزیت، از رابطه جنسی خودداری کنید.
نکته مهمی که باید درک کرد این است که دارو فقط ممکن است رایجترین انواع کاندیدا را که با عفونتهای مخمر واژن مرتبط است، درمان کند و سایر عفونتهای مخمری یا هر نوع واژینیت دیگر را درمان نمیکند. اگراز علت واژینیت کاملاً مطمئن نیستید، به پزشک مراجعه کنید. ممکن است هزینه خرید داروی اشتباه را پس انداز کنید و از تأخیر در درمان واژینیت خود و یا احتمالاً بدتر شدن آن، جلوگیری کنید.
هنگام خرید داروی بدون نسخه، حتما قبل از استفاده از محصول، تمام دستورالعملها را به طور کامل بخوانید. حتماً از همهی دارو استفاده کنید و فقط به دلیل برطرف شدن علائم، مصرف آن را متوقف نکنید.
در موارد زیر نیز حتماً به پزشک خود مراجعه کنید:
- همه علائم به طور کامل از بین نمیروند.
- علائم بلافاصله یا اندکی پس از پایان درمان بازگشت میکنند.
- شما هر گونه مشکل پزشکی جدی دیگری مانند دیابت دارید.
- شما ممکن است باردار باشید.
- شما یک شریک جنسی جدید دارید و نگران STI هستید.
واژینیت غیر عفونی با تغییر در علت احتمالی درمان میشود. اگر اخیراً صابون یا شوینده لباس خود را عوض کردهاید یا یک نرم کنندهی پارچه اضافه کردهاید ممکن است برای جلوگیری از باقی ماندن علائم ، استفاده از محصول جدید را متوقف کنید. همین دستورالعمل برای اسپری واژن، دوش، دستمال بهداشتی یا تامپون جدید نیز، اعمال میشود. به طور کلی ، هرچه مواد شیمیایی و فرآوردههای کمتری در معرض پوست حساس واژن قرار داشته باشد، بهتر است. اگر واژینیت به دلیل تغییرات هورمونی باشد، گزینههای مختلف هورمونی برای کمک به کاهش علائم در دسترس است.
درمورد درمان واژینیت چه سوالاتی را باید از پزشک خود بپرسم؟
مهم است که از دستورالعملهای پزشک و همچنین دستورالعملهای همراه با دارو پیروی کنید. با از بین رفتن علائم ، مصرف دارو را قطع نکنید. از پرسیدن سوال از پزشک خود خجالت نکشید. واژینیت از هر نوع، بسیار شایع است. سوالات خوب برای پرسیدن شامل موارد زیر است:
- آیا باید در طول درمان از رابطه جنسی پرهیز کنم؟
- آیا شریک زندگی جنسی من باید همزمان درمان شود؟
- آیا داروی این واژینیت با داروهای دیگر من تداخل دارد؟
- آیا در طول دوره قاعدگی باید کرم واژن یا شیاف را ادامه دهم؟
- آیا نیاز به بررسی مجدد دارم و اگر چنین است، چه زمانی؟
عوامل خطر برای عفونت کاندیدای واژن چیست؟
- درمان اخیر با آنتیبیوتیکها
- دیابت کنترل نشده
- بارداری
- پیشگیری از بارداری با استروژن بالا
- اختلالات موثر بر سیستم ایمنی بدن (مانند HIV و پیوند اعضا)
- اختلالات تیروئید یا غدد درون ریز
- کورتون درمانی
- دوش واژن
چگونه می توانم از ایجاد واژینیت جلوگیری کنم؟
کارهای خاصی وجود دارد که میتوانید انجام دهید تا احتمال واژینیت کاهش یابد. اگر از عفونتهای مخمری رنج میبرید، اجتناب ازپوشیدن لباسهایی که گرما و رطوبت را در خود نگه میدارند معمولاً مفید است. پوشیدن شورت نایلونی، جوراب شلواری بدون صفحه پنبه ای و اسپندکس تنگ یا شلوار جین ممکن است منجر به عفونت مخمری شود. بهداشت مناسب نیز مهم است.
شواهد علمی کمی وجود دارد که نشان میدهد، ماست و پروبیوتیکهای حاوی لاکتوباسیلوس باعث کاهش عفونتهای واژن میشوند. برخی نیز توصیه می کنند برای جلوگیری از رشد مخمر، خوردن غذاهای شیرین را محدود کنید.
از آنجا که برخی مواد میتوانند باعث تحریک واژن شوند، بیشتر پزشکان اسپریهای واژن یا صابونهای بسیار معطر را برای پاکسازی این منطقه توصیه نمیکنند. به همین ترتیب، دوش گرفتن مکرر ممکن است باعث تحریک واژن شود. مهمتر از آن، ممکن است عفونت واژن را پنهان کند.
اقدامات ایمن جنسی می تواند به جلوگیری از انتقال بیماری بین شریک زندگی کمک کند. استفاده از کاندوم در این میان از اهمیت ویژهای برخوردار است.
اگر به دوران یائسگی نزدیک میشوید، تخمدانهایتان برداشته شده یا به هر دلیلی میزان استروژن کمی دارید، با پزشک خود در مورد استفاده از قرصها یا کرمهای هورمونی برای روانکاری و سلامت واژن صحبت کنید.
عادتهای خوب سلامتی نیز مهم هستند. یک معاینه زنان و زایمان کامل، از جمله غربالگری سرطان دهانهی رحم در فواصل منظم با پزشک خود انجام دهید.
منبع: www.webmd.com